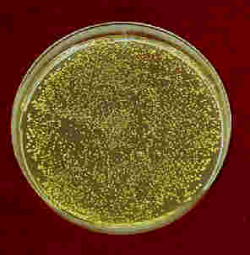

| 試験片の写真撮影 マクロ撮影(接写) |
||||||||||||||
| 材料の強さの実験をしていると、試験片や破面の写真撮影が必要とされ、顕微鏡ほどの倍率は必要無いが、そのままのカメラ機材では倍率が足りないことが起こってくる。この場合、撮影技術とライティング技術などが必要とされる。カメラは一眼レフ、レンズは接写用のレンズ、接写リング、ベローズアタッチメントなど撮影したい倍率によっては必要となる。表面の凹凸をピントが合った状態で撮影したいため、絞りの値は絞り(小さな値)、焦点深度(焦点が合う範囲)を深くして撮影する。金属顕微鏡の対物レンズをカメラに取り付けるアダプターを製作しこれで撮影したこともある。 また、金属などを撮影するときの反射などを防ぐため、ライティングは工夫を必要とされる。ライトの前にトレッシングペーパーで作成したスクリーンを置いたり、あるいは小型の対象物の場合、B4サイズのトレッシングペーパーを円筒形に丸めて、その中に撮影対象物を置き、円筒形の外からライティングして、円筒形の上から撮影する。 以前はフィルムカメラで、撮影条件を決めるために、シャッタースピード等変えて試し撮りし、フィルムを現像し、最適な条件を決めていた。 |
||||||||||||||
| (1) 金属の腐食孔の撮影例 | ||||||||||||||
| カメラは一眼レフカメラ、レンズは接写可能なマイクロレンズ。カメラを上下可動な取り付け台を有する接写台に取り付ける。シャッターにカメラのぶれを避けるためと数秒間解放にするのでレリーズを取り付ける。接写台は左右に、位置が自由に変えられるアームに取り付けられた照明のためのライトが付属している。 Mainのライトの腐食孔からの距離d1、高さh1、投光角度θ1を適切に調節し、腐食孔に影が出来、立体的に見えるように決める。Mainのライトだけですとコントラストが強すぎるので、反対側からSubの照明を使う。距離d2をMainのd1より大きく取ることで、照度を弱めにするのがこつです。また、Mainのライトで出来た強い影を、コントラストを弱くするために薄めるようにします。このライトも立体感を最も表す位置に調節して決める。慣れないと最初は苦労するがすぐ慣れます。孔食底の様相の情報を失うことなく、黒くならずに撮影することが重要です。焦点深度を深くするため(焦点が合う範囲を広くする)絞りは、1/16に設定し、ASA100のネオパンSSのフィルムで7,8秒の解放で(7,8秒レリーズを押して、シャッターを開けている状態)撮影していました。普通の状態での撮影では、1/250 秒と短い時間のシャッタースピードですが。 腐食孔の場合は光は錆のため、余り反射しないが、金属の場合は反射するのが一般的なので照明の前にすりガラスを入れる。すりガラスは重いので、A3かB4サイズのトレッシングぺーパーを針金の枠に張って立てられるように自作したものが使いやすい。小型の対象物の場合、A3かB4サイズのトレッシングペーパーを円筒形に丸めて、その中に撮影対象物を置き、円筒形の外からライティングして、円筒形の上にカメラを配置し撮影する。 実験の場合の写真は撮影対象物が、反射せず、立体感があるように、撮影し、撮影対象物の情報を100%記録することにあります。 |
||||||||||||||
|
||||||||||||||
| (2)金属顕微鏡での組織写真の撮影 | ||||||||||||||
| カメラに顕微鏡用のアダプターとレンズを取り付けてから、カメラを鏡筒に取り付けます。カメラのファインダーを覗きながらステージを上下させてピントを合わせます。投光器の強さ(電圧)をダイヤルを回して調節します。わずかに像が見える程度の明るさにして撮影したと記憶しています。シャッタースピードは7~8秒程度でした。これも組織により異なりますので、明るさと撮影時間をいろいろ変え、試し撮りをして最適な条件を求めます。 | ||||||||||||||
|
||||||||||||||
| (3)透明な高分子材料中にあるガラス繊維の撮影 顕微鏡の場合 |
||||||||||||||
| 複合材料の試験片内部のガラス繊維から剥離や高分子材料の変形の様相を撮影するための方法を考えたもので、図のように試験片の側面からフレッキシブルアーム付きグラスファイバー照明装置を使い照明し、金属顕微鏡に取り付けたカメラで撮影する。ガラス繊維の直径は10ミクロン程度である。 |
||||||||||||||
 図9 |
||||||||||||||
| ガラス繊維で強化された高分子材料は軽量で強度があり、腐食しにくい特徴があるが、強度にばらつきがある。これは、ガラス繊維と母材の剥離に原因があり、剥離すると強度はがた落ちになる。この剥離の様相を明らかにするために、透明な高分子材料に少量のガラス繊維を複合させて、繰り返しの荷重の下で、観察を行った。透明なガラス繊維と透明な母材のため、撮影には特別な配慮が必要とされた。 次の写真(図10 )は、複合材料のガラス繊維の剥離箇所から最大せん断応力面に発生したクレイズ(高分子材料の鎖が引き延ばされ、空孔が発生)と空孔が連結してき裂化した状態の写真である。(a)は横方向に繰り返し荷重が作用したものである。 (b)の写真は別角度から撮影した写真で、蝶番型に90°をなすせん断き裂であることから、蝶番型せん断き裂と名付けた。 (c)の写真でき裂先端領域は完全に空孔が連結して無く、クレイズの状態である。 |
||||||||||||||
|
||||||||||||||
|
||||||||||||||
|
||||||||||||||
| 図10 蝶番型せん断き裂 |
||||||||||||||
 |
||||||||||||||
| 図11蝶番型せん断き裂の形状 ガラス繊維が長いほど枚数が多いせん断き裂 | ||||||||||||||
| 最初に観察できたのは(c)の写真で、次に破面観察で(d)の写真が得られた。この写真から立体的にせん断き裂のある形が推察され、これを明らかにするため、(a)(b)(e)の写真を得て、(f)の模式図に表すことができた。(e)の写真のように羽のようなせん断き裂が90°傾いて発生しており、材料力学の最大せん断応力面の説明もできる。実験に於ける写真もこのような使い方もあるために図10を掲載した。写真(a),(b)、図9のライティングはオリジナルな方法である。 *図11までの写真はすべてフィルムです。自分で現像、焼き付け |
||||||||||||||
| * 接写するとき、撮影対象物の背後の反射しない材料として、書道用の下敷き(羅紗布?)が最適で、黒と藍色と濃い小豆色の3枚で使い分けている。 撮影対象物とバックのカラーの組み合わせで説得力も変わってくると思っている。 |
||||||||||||||
| * 図13のような道具などの写真は晴天の日、建物の影で逆光になるように撮影した方がよい場合がある。図12の写真はそのように撮っていないので若干影が出来ている。 |
||||||||||||||
|
||||||||||||||
| *ディジタルカメラで接写した経験が余りないが、ディジタルカメラには、レリーズは使えないようですので、シャッタースピードを数秒に設定して、セルフタイマーでシャッターを切る方法となるのか。レリーズがない場合、シャッターを押すときにカメラがぶれ、焦点が合わなくなる可能性がある。 | ||||||||||||||